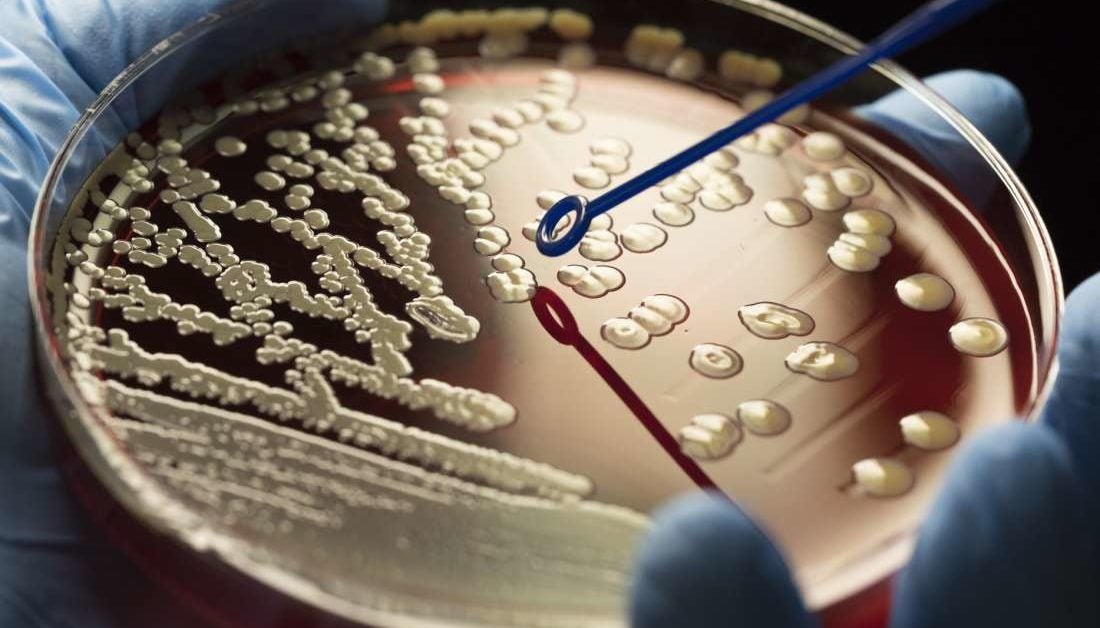
Fosamax Side Effects Femur Fractures Fda  Lawsuit

The rapid emergence of resistant bacteria is occurring worldwide, endangering the efficacy of antibiotics, which have transformed medicine and saved millions of lives. 1 6 many decades after the first patients were treated with antibiotics, bacterial infections have again become a threat. 7 the antibiotic resistance crisis has been. Fosamax® once weekly alendronate sodium. 70 mg tablet. what is in this leaflet. this leaflet answers some common questions about fosamax. Fosamax: alendronate belongs to a family of medications known as bisphosphonates. it is used to treat and prevent osteoporosis for postmenopausal women. Insulin resistance is a health condition in antibiotics resistance crisis which your body’s cells become resistant to the effects of the hormone insulin, which acts to regulate the levels of glucose (sugar) in your body. lifestyle changes such as altering your diet and.
Do you need a drug for osteoporosis? harvard health.
Fosamax Alendronate Side Effects Interactions Uses
The advent of multidrug resistance among pathogenic bacteria is imperiling the worth of antibiotics, which have previously transformed medical antibiotics resistance crisis sciences. the crisis of antimicrobial resistance has been ascribed to the misuse of these agents and due to unavailability of newer drugs attributable to exi. Policymakers have warned that we face an antibiotic resistance crisis. why is this, what are researchers doing to address it, and what can we do right now? while medical research has helped us overcome many health threats, we now face a new. Fosamax is a brand-name prescription medication. it’s fda-approved for the following uses in adults: prevent or treat osteoporosis (a condition that causes brittle, weak bones) in women who’ve gone. How to use fosamax oral read the medication guide provided by your pharmacist before you start taking alendronate and each time you get a refill. follow the instructions very closely to make sure.

The crisis of antimicrobial resistance has been ascribed to the misuse of these agents and due to unavailability of newer drugs attributable to exigent regulatory requirements and reduced financial inducements. New research finds that a cranberry extract enhances the effectiveness of antibiotics in the fight against drug-resistant bacteria. new research finds that cranberry molecules make bacteria more sensitive to antibiotics and reveals the twof. Fosamax (alendronate) was released by merck & co. in 1996. it’s primary function is to increase bone density. the drug is in a category known as nitrogenous bisphosphonates. other drugs that fall into this category are used for various treatments such as chemotherapy.
Misuse and overuse of antibiotics have contributed to antibiotic resistance, a phenomenon that reduces or eliminates the effectiveness of antibiotics the. gov means it’s official. federal government websites often end in. gov or. mil. before. Bisphosphonates are a class of osteoporosis drugs such as boniva (ibandronate), fosamax (alendronate), actonel (risedronate) and reclast (zoledronic acid). their mode of action is to disrupt normal bone remodeling, which is ultimately detrimental to bone integrity and fracture resistance. There are many types of antibiotics available, including topical antibiotics, natural ones and prescription antibiotics. topical and natural antibiotics may be available over the counter, but the list of most common antibiotics that need to. Decades after the first patients were treated with antibiotics, bacterial infections have again become a threat because of the rapid emergence of resistant bacteria-a crisis attributed to abuse of these medications and a lack of new drug development.
The Antibiotic Resistance Crisis
Do You Need A Drug For Osteoporosis Harvard Health

Fosamax prices and fosamax coupons goodrx.
Learn when to use antibiotics to prevent antibiotic resistance the. gov means it’s official. federal government websites often end in. gov or. mil. before sharing sensitive information, make sure you're on a federal government site. the site. New research uses nanocapsules that contain curcumin, the main ingredient in turmeric, to tackle antibiotic resistant strains of helicobacter pylori. researchers around the globe are scrambling to find ways to tackle the superbug crisis. no. Crisis looms in antibiotics as drug makers go bankrupt first big pharma fled the field, and now start-ups are going belly up, threatening to stifle the development of new drugs. dr. ryan cirz, a. Antibiotic resistance (ar), when germs do not respond to the antibiotics resistance crisis drugs designed to kill them, threatens to return us to the time when simple infections were often fatal. cdc is committed to protecting people and the future of the healthcare, ve.
The antimicrobial resistance (amr) crisis is the increasing global incidence of infectious diseases affecting the human population, which are untreatable with any known antimicrobial agent. this crisis will have a devastating cost on human society as both debilitating and lethal diseases increase in frequency and scope. A spanish geneticist puts forward the hypothesis that the stress created by overusing antibiotics forces non-resistant bacteria to take up the dna of resistant ones. why are bacteria becoming increasingly more resistant to antibiotics? a hy. See more videos for antibiotics resistance crisis. Oct 19, 2020 · find everything you need to know about fosamax (alendronate), including what it is used for, warnings, reviews, side effects, and interactions. learn more about fosamax (alendronate) at.
Antibiotic resistance crisis is happening now and it seems like there is no solution to it yet. everyone knows that the antibiotic resistance is elevating to dangerously high levels in all parts of the world. the antibiotics that were used to antibiotics resistance crisis save millions of lives are no longer effective towards the swift emergence of resistant bacteria. Oct 19, 2020 what are the side effects of fosamax (alendronate)? · heartburn, upset stomach; · stomach pain, nausea; · diarrhea, constipation; or · bone pain, . Antibiotic resistance is one of the biggest threats to global health, food security, and development today. antibiotic resistance can affect anyone, of any age, in any country. antibiotic resistance occurs naturally, but misuse of antibiotics in humans and animals is accelerating the process. 11/19/17 call 800-232-4636.
Antibiotic resistance is a growing public health concern worldwide. when a person is infected with antibiotics resistance crisis an antibiotic-resistant bacterium, not only is treatment of that patient more difficult, but the. Antibiotics can save lives. but when they are not used correctly they can become less effective. avoid antibiotic resistance by reading more. antibiotics are medicines that fight bacterial infections. used properly, they can save lives. bu. Antibiotic resistance is one of the biggest public health challenges of our time. each year in the u. s. at least 2. 8 million people get an antibiotic-resistant infection, and more than 35,000 people die. fighting this threat is a public health priority that requires a collaborative global approach across sectors.
0 komentar:
Posting Komentar